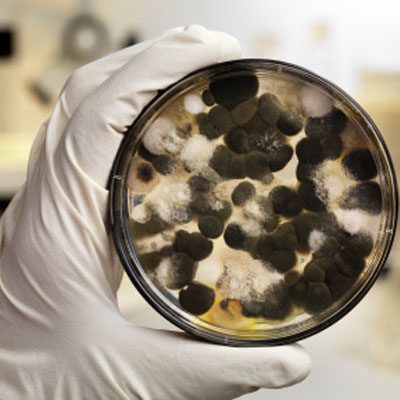
mold testing in Columbus ohio

Quality Mold Inspection Service in Columbus Ohio
You might be surprised to learn how easy it is for mold to invade your home without even noticing. Often times, mold can form in basements, ceilings, behind walls and other places that you simply don’t see on a regular basis. By the time signs of mold have become visibly apparent, you may have a major problem on your hands. The best way to detect and address potential mold problems is by having Home Inspections LLC inspect your home for mold. They will be able to identify what types of mold are present and how pervasive the problem is in the Columbus Ohio area. Therefore, will help you decide on the right course of action. If it seems like your allergies are worse than ever, your symptoms may not be the simply tied to seasonal changes. You could be living with mold and your health could be suffering. Get to the root of the problem with a hassle-free and affordable mold inspection. Call us Today and Schedule a Mold Inspection in Columbus Ohio.
Call and Schedule Your Service Now
Don't wait! Dial 1-800-241-0133 to schedule a home mold inspection in Columbus Ohio
What is Mold?
Molds are fungi that grow on surfaces, in porous materials, and on or within living organisms and decaying organic matter. The wide world of mold is made up of virtually thousands of species and subspecies. Some are found in soils or tree bark, while others are happiest setting up shop in our homes and businesses in Columbus, Ohio.
Mold reproduces by sending tiny spores through the air to find another place to colonize. Colonies can be virtually any color and range from kind of fuzzy to downright slimy. Mold is a champion of nature; it plays an important role in the decomposition of dead matter to create fertile earth for new growth. Outside, you are exposed to small amounts of airborne mold spores every day with no side effects, and at that level, there isn’t any need for concern. However, under optimum conditions, mold can grow out of control, and exposure to mold at these levels can leave you feeling sick and miserable.
You might be surprised to learn how easy it is for mold to invade your home without you even noticing. It can form in basements, bathrooms, ceilings, behind walls, and in other places you simply don’t see regularly. But it’s the nature and magnitude of mold that are the most important considerations—by the time signs of mold have become visibly apparent, you may have a major problem on your hands.
Mold on the drywall found during a mold inspection in Columbus Ohio
Mold in attics found during a mold inspection in Columbus Ohio




What Is That Smell?
At every stage in its life cycle, mold is a biological contaminant. Molds create volatile compounds that are easily released into the air. These floating particles produce the strong, musty odor commonly associated with mold growth.
How Does Mold Grow?
Spread by the release of microscopic spores, molds thrive in damp, humid conditions. Most fungi are composed of microscopic filaments called hyphae, which branch out to eventually form a network called a mycelium. The mycelium extends over or through whatever substrate the fungus is using as a source of food. Fungi secrete digestive fluids that decompose the substrate to make nutrients available. When the environmental conditions are right, molds and fungi have all the food they need to grow and colonize.
Meet the Enemy—the Different Species of Mold
Common Household Molds
Species such as Penicillium, Aspergillus, and Cladosporium are extremely common in Columbus, Ohio, and are widely found in man-made structures. They will grow on most surfaces on nothing more than the humidity in the air and are known to cause allergic symptoms.
Black Mold and Other Toxic Molds
Toxic black mold or black mold is a name commonly used for Stachybotrys chartarum, which produces toxic substances called mycotoxins. It is one of the most infamous toxic molds because it grows in homes and is extremely dangerous to humans. This is the stuff nightmares are made of—it’s the monster you see on TV where they have to seal off the building and wear hazmat suits to remove it.
Basidiospores and Memnoniella are also toxic and present a serious health risk.
Water-Marking Molds
Water-marking molds, such as Chaetomium and Stachybotrys, show you exactly where the leaks are because they grow abundantly where there is a water source.




The list below shows the molds we look for during our inspections in Columbus, Ohio:
- Alternaria: A common indoor allergen for humans, causing hay fever or hypersensitive reactions that sometimes lead to asthma.
- Ascospores: Common in outdoor gardens.
- Basidiospores: Spores produced by a class of fungi called basidiomycetes. They can produce a variety of toxins and cause hay fever, asthma, eczema, pneumonitis, allergic alveolitis, fatigue, and runny nose.
- Bipolaris/Drechslera: These groups of fungi cause allergic fungal sinusitis.
- Botrytis: An airborne fungus that attacks houseplants. This fungus can cause allergies, hay fever, asthma, and hypersensitivity pneumonitis.
- Chaetomium: A common water marker that usually indicates wet drywall or wet paper.
- Chartarum (a.k.a. black mold): A well-known mold featured in TV programs such as 60 Minutes and in internet hype; not all subspecies are toxic. These species need a direct water source to grow, such as a leaking window or roof or faulty plumbing.
- Cladosporium: The most common mold species found during an inspection; it is considered to be an allergen.
- Curvularia: Another common allergenic species.
- Epicoccum: Often found growing on building materials, including paper and textiles, and insects. Can cause hay fever and asthma.
- Fusarium: Often found on rotting vegetation and can cause allergic reactions. You’ll find it on that potato that fell behind the shelf and on dead houseplants.
- Memnoniella: A sister mold to Stachybotrys, the two species will often grow together. It is also considered toxic.
- Penicillium/Aspergillus: The most common mold species to show up in an indoor mold inspection. Most of the hundreds of subspecies are allergens, with only a few that are toxic. This group of species will grow with only the air’s humidity as its water source. An A/C failure will allow this mold to grow on walls, furniture, and clothing.
- Stachybotrys: An excellent water marker and the most common toxic mold species.
- Stemphylium/Ulocladium: Often found in soil, wood, and decaying vegetation. Some species found on leaves are plant pathogens. Some people may experience hay fever or asthma.
The Toxic Health Effects of Mold
Mold is more than just unpleasant to look at. Not only can it permanently damage your home but also it can seriously affect your health. Some molds are toxic and cause serious medical conditions. Most molds badly affect people with existing allergies or asthma and, if there are enough spores in the air, can irritate your eyes, nose, and throat.
When mold levels are elevated and there is chronic exposure in the home, side effects can run the gamut from mild to serious. These can include sneezing, a runny or stuffy nose, coughing, wheezing, shortness of breath, tightness of the chest, skin irritation, asthma, respiratory infection, and toxic poisoning. Individuals with suppressed immune systems may be particularly vulnerable to illnesses caused by mold contamination.
What is a Certified Mold Assessor?
A certified mold assessor (CMA) in Columbus, Ohio, is a fully licensed and insured professional who is trained to meet specific state requirements for licensure and who has completed at least 24–32 hours of education in advanced mold assessment techniques, including mold, water, and respiratory protection (PPE). CMAs undergo extensive hands-on training, including sampling processes, PPE, building containment, establishing negative pressure, and fresh air makeup.
CMAs specialize in locating the origins of mold and mildew, other toxic chemicals (VOCs), and general indoor air quality problems—detecting the presence, form, and source of mold using cutting-edge technology.
What Does a CMA Do?
A CMA performs an examination following the guidelines of the National Organization of Remediators and Mold Inspectors (NORMI). This experienced professional develops an indoor air quality (IAQ) profile using investigative techniques and writes protocol for either sanitization or remediation based on IICRC S500, IICRC S520, NYC Guidelines, EPA Standards, and the NORMI Professional Practices.
Why Do You Need a CMA?
Why do you need a mold assessor? Why not just remove the mold without testing? A mold assessor will accurately evaluate your situation even when the mold is not apparent or visible. Mold testing also identifies which species of mold has invaded your Columbus, Ohio, home so a remediator can choose the correct product for sanitization.
Testing for Mold and Indoor Air Quality
Why Do I Need an Indoor Air Quality Mold Inspection Test and Sampling?
Mold growth is a common problem that can cause a whole host of health issues. If you have recently experienced any flooding because of record rainfall or plumbing problems, you will want to have your home tested. Even persistently high levels of humidity can cause moisture to build up and create the perfect breeding ground for mold and fungi. While you may notice visible signs of mold accumulating in damp, dark places, airborne mold spores are too small to see. Therefore, you could be exposed to mold without realizing that your air is contaminated.
If you are experiencing respiratory or other health problems, it is a good idea to have your home tested. Your issues could be the result of mold, and the consequences can be far-reaching. It is also a wise decision to invest in a mold inspection if you live in a region with high humidity or you are noticing a build-up of condensation in your home and HVAC system.
Working with a mold expert in Columbus, Ohio, will help ensure your home is tested correctly using the best possible methods.
Different Types of Mold That Can Be Found in your Home





What Is an Indoor Air Quality Mold Inspection Test?
By far, the most common and least intrusive way to test for mold is through an air quality test. Air samples test for mold and air quality because mold spores are small enough that they cannot be seen with the naked eye. Testing indoor air samples is the best way to identify the types and concentrations of mold in your home. This type of testing is minimally intrusive and allows the expert to quickly collect samples.
The Air-O-Cell Air Sampling cassette is a sampling device designed for the rapid collection and analysis of a wide range of airborne aerosols. These include fungal spores, pollen, insect parts, skin cell fragments, fibers, and inorganic particulate. The mold inspection device is placed in the center of the room where experts suspect mold is growing. Next, an air pump works to collect air samples. The entire process is repeated in at least two rooms to ensure accurate readings and help pinpoint the exact location of the mold.
The typical mold inspection will last no more than 30 minutes and will gather enough air to send to the lab for analysis. The samples are incubated in a petri dish before being tested.



Lift Test Sampling
While collecting an air sample is an easy and effective way to test during a mold inspection, in some cases, a mold lift test is a more appropriate choice. Your inspector will collect spores that have settled on indoor surfaces.
A mold lift test can provide vital information, including how far mold spores have traveled from the source, whether mold growth is microscopic and not yet visible, and whether the mold has contaminated other areas, such as your HVAC system.
If a mold lift test is necessary to determine the breadth of your mold problem, rest assured the process is straightforward. A specialist will use a testing strip that has a sticky surface to carefully collect samples from surfaces throughout your home. It is important to handle the samples carefully and store them properly to avoid contamination that can produce inconclusive results.
Our Columbus, Ohio, technicians are well versed in sampling best practices that ensure every sample arrives at the laboratory completely intact. While there are DIY mold lift kits on the market, they don’t come close to the level of accuracy that our experts can provide. With such affordable prices, it makes sense to take advantage of years of experience that will ensure that the test is done right the first time. If you have mold in your home, the last thing you want to do is waste time and money while also compromising your health.
Swab Test Sampling
Similar to the lift test, a wetted swab is pressed against the moldy surface to collect a sample that is then carefully sealed and sent to the laboratory for analysis.
Bulk Sampling
Finally, more extreme cases of mold may require bulk sampling where large pieces of material are removed for inspection.
Testing for mVOCs and VOCs
Airborne chemicals can be monitored to determine the level of actively growing mold in the house. A Home Air Check measurement is an excellent way to determine the level of mold growing in a house—even behind walls. This is possible because the Home Air Check is a chemical analysis of the air, and chemicals move more freely through a house than mold spores (particulates) which can be trapped by walls and thereby go undetected.
What are mVOCs?
Microbial volatile organic compounds (mVOCs) are chemical gases produced during fungal growth as waste byproducts. Just as humans expire gases, so do molds. They elevate primarily when mold is in an active state, and their production is dependent on the substrate and environmental conditions. These chemicals can be easily detected (even when no visible mold is present) and monitored to determine the level of actively growing mold in the house.
What are VOCs?
We also test for volatile organic compounds (VOCs), which are invisible gases emitted from solids and liquids found in the home, such as building materials, cooking sources, gasoline and fuel, air fresheners, paints/varnishes, dry cleaning, laser printers, carpeting, adhesives, cleaning solutions, and many other sources. These chemicals can build up in houses, especially in the winter and summer months when homes are generally closed up.
Repeated exposure to VOCs can cause blurred vision, headaches, nausea, dizziness, coughing, lethargy, burning eyes, respiratory irritation, skin rashes, reduced lung function, respiratory illness, concentration difficulties, depression, and, in extreme cases, loss of consciousness and suffocation. Higher exposure can lead to liver and kidney damage and central nervous system irregularities. Some VOCs can cause cancer.
Indoor Air Quality in a Commercial Setting
We check mold and indoor air quality in commercial buildings, hotels, offices, retail stores, and government facilities. Our commercial inspections include:
- Mold inspections and mold testing
- Indoor air quality assessments
- Carbon dioxide, carbon monoxide, temperature, and humidity testing
- Volatile organic compounds
- Ultrafine particulate testing
- Indoor allergen testing
- Bacterial contamination testing
Indoor air quality is a significant concern for employees in a work environment. Home & Commercial Inspections LLC’s key purpose is to promote environmental well-being and health and safety in indoor workplaces. Mold formation, as well as fungal growth inside air-conditioning systems and duct work, can significantly impair an office or retail environment’s air quality.
Home & Commercial Inspections LLC can evaluate your commercial office or retail space to determine if employee complaints are justified. If a mold or other indoor air quality issue is discovered, one of our inspectors will liaise with the maintenance personnel, safety professionals, or building owner to prepare a management and remediation plan or operations and maintenance plan.
We have the know-how and experience to uncover mold and other indoor air quality problems in all commercial buildings, from small office suites to high-rise office complexes to hotels. Our professional environmental inspection services include:
- Carbon dioxide, carbon monoxide, and temperature and humidity testing: Carbon dioxide is a natural component of human respiration and is only hazardous at very high concentrations. A sudden rise in carbon dioxide levels shows that there isn't enough fresh air in the building; occupants may feel stuffy and tired. Temperature and humidity are also important comfort factors. Mold, particularly in air-conditioning, and dust mites are both affected by humidity. Carbon monoxide is a harmful byproduct of combustion. Some of the most common indoor air quality issues include inadequate ventilation, temperature, and humidity regulation.
- Volatile organic compound testing: A specialized test that assesses the overall quantity of volatile organic compounds. Many industrial chemicals and cleaning products include volatile organics, commonly responsible for aromas. Many VOCs are irritants or poisonous. VOC monitoring is extremely helpful to check if neighboring industrial activities or chemical usages are harming indoor air quality.
- Ultrafine Particulate Testing: Particulate matter can irritate the respiratory tract. We check whether dust levels are within acceptable levels. Ultrafine particles can emit from a variety of equipment and processes, such as toner copiers and printers, water heaters, furnaces, and boilers.


Indoor Air Quality in Schools and Day Care Centers
Many school buildings are old and in poor condition, which can affect indoor air quality and impact the health, performance, and comfort of children and staff. Managing indoor air quality in schools creates a unique set of issues: Students and teachers work in close proximity, and with the same amount of floor area, a typical school has around four times the number of tenants as an office building. Schools also have a significant number of heating, ventilation, and air-conditioning units, putting additional demand on maintenance personnel.
Most people spend about 90 percent of their time inside, and the US Environmental Protection Agency (EPA) studies of air pollutants report that indoor pollutant levels may be two to five times (and sometimes more than 100 times!) higher than outdoors.
Poor indoor air quality can affect student and teacher performance; hinder trust; create liability issues; and cause health problems, such as headache, fatigue, asthma, nausea, and skin, eye, nose, and throat irritations.
Home & Commercial Inspections LLC provides specialized assessments of the indoor air quality of your Ohio school, ensuring the optimum health and safety of students and staff.

CMA Report & Protocol
A mold inspection lab result report will help you establish a plan of action. The air quality results will include an explanation of the findings and recommendations for addressing any problems. Our detailed report will tell you the source of the problem, the species of mold, and the nature of the infestation. We will discuss the results with you and recommend a resolution. We will also provide follow-up clearance testing.
Mold removal in Columbus, Ohio, can be an expensive process that must be performed by a company that specializes in this type of work. Our detailed analysis will aid the process, thereby reducing costs.
CMA Sample Report Link
Click here to see an example of a CMA report.
Prevention and Control
Mold loves water. Keeping your home or business dry is the most important thing to preventing the growth of mold.
Keeping Mold at Bay
Removal of mold at home or work can be an essential task, and remediation can be expensive if the mold is pervasive. The best way to prevent mold problems is, first of all, to stop them from happening. Here are few tips on mold prevention:
- Address urgent leaks. Repair leaky drains or holes in the roof to keep moisture out of your house.
- Clean and dry problem areas immediately. If your pipes leak or condensation drips from your air conditioner, remedy the problem and dry any damp surfaces within 24 to 48 hours. Mold needs persistent moisture, so it is important to dry the area quickly.
- Maintain a steady level of humidity. Extremely moist air may provide sufficient moisture to sustain mold growth on certain surfaces. Whenever convenient, use a dehumidifier in your basement and air conditioning. Ventilate the bathroom and toilet. This will serve to regulate temperature and humidity levels.
- Prevent cold, isolated surfaces such as windows, pipes, doors, external walls, or ceilings from being condensed.
- Use paints pretreated with mold killer.
- Clean and dry hard surfaces with a moderate detergent and water solution.
Mold Removal (Remediation)
Mold removal, also called mold remediation, is the process of removing mold and its spores from your home or company. Since dead mold spores are still irritants, mold remediation does not destroy the mold. Mold removal protocol differs depending on each situation, but it is based on the following principles:
- The infected area is isolated and contained.
- Airborne spores that may be disturbed during the process are controlled.
- Mold-affected surfaces are vacuumed with a HEPA vacuum.
- Mold-contaminated objects are cleaned and removed.
- Unmovable structures are sprayed and scrubbed.
- The area is disinfected, deodorized, encapsulated, and rebuilt.
- The air is “scrubbed” to eliminate residual spores.


What Does a Mold Assessment Cost?
Mold testing costs in Columbus, Ohio, vary by region and by contractors. A mold evaluation will cost about the same as a regular home inspection, which is done before you purchase a new home. For small- to medium-sized houses (below 4,000 square feet), mold inspections normally cost between $300 and $400. Over 4,000 square feet, the costs range from $700 to $900.
Most major insurance companies will cover the fees associated with mold inspections, mold testing, and mold remediation.
If you choose HC Inspections for the remediation process to rid your house of mold, our mold assessment is free of charge.
Contact Home & Commercial Inspections for the CMA inspection today.
Have Questions About a Mold Inspection in Columbus Ohio?
Request a mold inspection in Columbus OH. Fill out the form below and we will give you a prompt reply.
"*" indicates required fields
Primary Service Areas for Mold Inspection
Mold Inspection Throughout Columbus Ohio and Central Ohio
Give us a call for top quality Mold Inspection in your Columbus Ohio and Central Ohio area! 1-800-241-0133!
Thorough Mold Inspection in Columbus Ohio
Home Inspections LLC: Mold Inspection
Your Mold Inspection in Columbus Ohio Can't Wait! Call us Today!
Dial 1-800-241-0133 to schedule a mold inspection for your Columbus Ohio home
It's not cute... Call for a mold inspection in Columbus Ohio now!
Our Reviews for Mold Inspection
We requested to work with Greg based on the reviews that we saw and were so glad that we did! He was very responsive via text/phone - on our scheduled day, he showed up early and began inspection right away. His inspection was very thorough and professional. As we walked through the house, he also gave us (as first-time home owners) lots of valuable home maintenance tips. We are recommending Greg and the company to our neighbors and friends, and we will also work with him again for our 11-month warranty inspection!
Greg was great! Super knowledgeable and very thorough. Spent the time to walk around the property with me and point things out / provide advice on maintaining appliances. Very satisfied!
We were so impressed with James from our previous home inspection a few years ago that we requested him again for our new home. He was great back then and still is now. He’s very thorough and informative and has gone out of his way to our answer questions and provide us additional information. He’s very professional and has a great friendly personality. If we ever need another inspection we’d definitely be calling him again.
